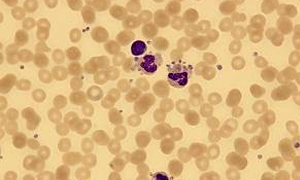

机体血液所含血小板低于10~30万/mm3即为血小板低。血小板低可见再障、白血病、血小板减少性紫癜多种血液病,治疗血小板低务必避免一味治疗,需得诊断清楚病症,方能对症治疗。
血小板低会致命吗?点此问医生
盘点血小板低治不对症的几大原因!
误诊、漏诊:血小板低病症复杂难辨,很多非正规医院检查患者血常规时,发现血小板低,就一味的按照血小板低病情治疗,诊疗过程中未能确诊是何种病症引起的血小板低。如果是再障,血小板减少性紫癜或白血病引起的,那么单纯的治疗血小板低,只是避重就轻。
治标不治本:临床上治疗血小板低常用激素、免疫抑制剂、脾切除的方法,这些方法都能短时间内迅速提升血小板,缓解患者出血的症状,但不除根,治疗一段时间,患者不仅产生耐药性,而且一旦停药或减量,血小板还会降下来,导致病情反复难以除根。再障也能引起血小板低吗?更多详情问医生
治疗见好就收:很多患者存在治疗一段时间,见好就出院的情况,这种情况导致病情不仅得不到巩固,还会加重病情,迁延难愈。患者应该在医生的指导下,谨遵医嘱,坚持治疗,病情才能在较短时间内康复。
趋利避害——***血小板低并不难
中西医结合治疗 1疗程止血3疗程升板 治疗血小板低疗效高
[精检测] 近年来,中西医结合治疗在提升血小板领域取得了显著成绩,为使更多患者受益,济南血液病医院率先推出血液细胞基因分型,对血小板低患者进行有效诊断。可根据病变细胞的强弱程度,基因类型确定血小板低具体病因和对应病症,为下一步制定对症治疗方案提供科学依据。您知道您的血小板低是由什么病引起的吗?问医生
[对症治疗] 在血小板低的具体治疗过程中,中西医结合治疗拒绝千人一方,采用“一人一方,专病专药”的治疗方式,有效避免了以往传统治疗方法单一,效果不稳定的弊端,集“权威检查、有效分型、差异治疗、愈后管理”于一体,充分保证疗效,将血小板低的治疗高效提升。
医生寄语:为方便广大患者就诊,济南血液病医院特开设网络预约绿色通道,患者可以通过网络免费预约挂号,省去排队挂号的麻烦同时还节约了挂号费用。如果您有疑问,请尽快拨打健康热线0531-86953333和医生交流咨询。
上一篇:血小板低如何治疗才能提升?
下一篇:哪里治疗血小板减少症最好?




济南血液病医院
咨询热线:0531-8695 3333
备案号:鲁ICP备12006985号
工信部链接:http://beian.miit.gov.cn